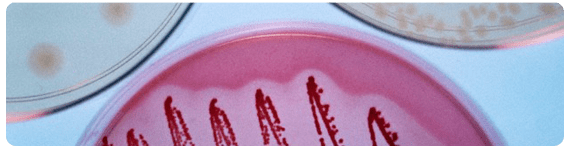
Los genomas de los alimentos interactúa con el genoma humano, ya sea directamente o mediado por la interfase con el metagenoma microbiano intestinal Los genomas de los alimentos interactúa con el genoma humano, ya sea directamente o mediado por la interfase con el metagenoma microbiano intestinal

Alimentos y bebidas son la materia física que administramos a nuestro cuerpo, además del aire inhalado, drogas y medicamentos. La nutrición representa así uno de los impactos ambientales más fuertes a largo plazo sobre la salud humana. La investigación nutriológica contemporánea se enfoca en la promoción de la salud, previniendo o retrasando el surgimiento de la enfermedad, optimizando el desempeño y valorando los beneficios y riesgos. Estas direcciones requieren de estrategias completas, debido a que los componentes alimentarios interactúan con nuestro cuerpo, no solamente a nivel de sistema, sino también a niveles de órganos, células y moléculas, y a que la mejora nutricional de un aspecto de la salud debe estar acompañado por la conservación de la salud en todos los demás aspectos.
Alimentos y bebidas son la materia física que administramos a nuestro cuerpo, además del aire inhalado, drogas y medicamentos. La nutrición representa así uno de los impactos ambientales más fuertes a largo plazo sobre la salud humana. La investigación nutriológica contemporánea se enfoca en la promoción de la salud, previniendo o retrasando el surgimiento de la enfermedad, optimizando el desempeño y valorando los beneficios y riesgos. Estas direcciones requieren de estrategias completas, debido a que los componentes alimentarios interactúan con nuestro cuerpo, no solamente a nivel de sistema, sino también a niveles de órganos, células y moléculas, y a que la mejora nutricional de un aspecto de la salud debe estar acompañado por la conservación de la salud en todos los demás aspectos.
La nutrición personalizada implica, en la práctica, el adaptar el alimento a las necesidades individuales. Aquellos productos alimentarios que atienden los requerimientos o preferencias de grupos específicos de consumidores están basados típicamente en investigación empírica más que en la nutrición molecular. La nutrigenómica y la nutrigenética conforman la base científica para comprender las contribuciones genómicas y genéticas a dichas preferencias, requerimientos y respuestas a la dieta, y se pueden desarrollar en medios futuros para que los consumidores puedan valorar su salud y su estado nutricio.
Los genomas de los alimentos codifican proteínas y péptidos bioactivos
Además de carbohidratos y lípidos, las proteínas representan una de las tres clases de macronutrimentos que son factores clave en cada proceso celular. Las enzimas son las proteínas que catalizan virtualmente cada reacción metabólica (por ejemplo, las enzimas digestivas pepsina y quimotripsina). Las proteínas también exhiben funciones estructurales y mecánicas (el citoesqueleto mantiene la forma celular, mientras que actina y miosina permiten el movimiento corporal). Adicionalmente, las proteínas participan en la señalización celular y en la respuesta inmune.
Las proteínas de los alimentos se componen de manera diferente de acuerdo a su origen, animal o vegetal. Por tanto, una dieta balanceada contiene proteínas de fuentes diferentes y complementarias para asegurar un abastecimiento balanceado de aminoácidos. La calidad nutricional de las proteínas está valorada a nivel de composición de aminoácidos, la digestibilidad de proteína y la habilidad de ser absorbida. El cuerpo requiere cantidades bastante altas de proteínas a fin de funcionar eficientemente, además de que las proteínas son continuamente sintetizadas y degradadas, un fenómeno denominado “rotación de proteína”.
Los proteomas de alimentos están bien caracterizados, cubriendo un amplio rango de fuentes de proteína animal y vegetal. Más que como macronutrimentos, las proteínas y péptidos son muy apreciados debido a su variedad de componentes bioactivos que ejercen funciones como factores de crecimiento, agentes hipotensores, antimicrobianos, modificadores de la ingestión de alimento o reguladores inmunes. Por ejemplo, los péptidos bioactivos de varias fuentes vegetales (como soya, arroz o girasol) pueden ser liberados por digestión enzimática in situ in vivo, o a través de procesamiento/fermentación, in vitro, ejerciendo varios efectos benéficos que van de la protección contra el estrés oxidativo excesivo, al cáncer, la vía cardiovascular y beneficios inmunológicos.
Los motivos biológicamente activos en las cadenas de polipéptidos son fragmentos que son inactivos en tanto residan en sus secuencias precursoras, pero al ser liberados por enzimas proteolíticas pueden interactuar con receptores y ejercer bioactividad. Los péptidos bioactivos pueden ser liberados durante la digestión por enzimas del anfitrión o enzimas microbianas. También pueden ser generados durante el procesamiento alimentario (procesamiento industrial) o la maduración (procesamiento natural). A fin de definir de manera precisa cuestiones de biodisponibilidad y bioeficacia, tanto sistémicamente (por ejemplo, en sangre) como localmente (por ejemplo, en el estómago y el intestino), los péptidos y proteínas bioactivos deben ser identificados y cuantificados desde la matriz del alimento hasta los tejidos objetivo (target) en el cuerpo. Los péptidos y proteínas bioactivos han sido ampliamente estudiados y existe una base de datos de péptidos bioactivos, que se ha establecido para la clasificación y determinación potencial de bioactividad de las proteínas alimentarias.
Péptidos bioactivos de los lácteos
La leche humana es la fuente que ha coevolucionado con los humanos para apoyar idealmente el crecimiento y desarrollo saludable neonatal y para favorecer la maduración y mantenimiento de un sistema inmune balanceado. Los bioactivos de la leche se derivan de sus proteínas y péptidos, lípidos y oligosacáridos, y estos están presentes en varias especies de mamíferos. El contenido de proteína en la leche humana puede dividirse en caseínas y suero, con una relación 50:50 pero/peso (w/w, por sus siglas en inglés), mientras que la leche bovina consiste de 80% de caseínas y 20% proteína de suero. La función de las caseínas es como portadores de hierro y precursores de péptidos bioactivos, mientras que las proteínas de suero exhiben funciones críticas en la modulación y defensa inmune. Por otro lado, las proteínas en lácteos y otros alimentos también representan una fuente de alérgenos potenciales o probados que pueden conferir riesgos a los consumidores susceptibles.
La leche humana está compuesta principalmente de caseínas, α-lactoalbúmina, lactoferrina, albúmina y varias inmunoglobulinas, y estas proteínas predominantes constituyen más del 99% de la masa de proteínas en la leche. La glicoproteína lactoferrina, una proteína de suero ligadora de hierro y abundante en los mamíferos, influye profundamente en el sistema de defensa del anfitrión; se ha demostrado que previene el crecimiento bacteriano por interacción directa entre la proteína y la membrana bacteriana Gram-negativo. Adicionalmente, lactoferrina y péptidos derivados de la proteína de longitud completa, también influyen en la producción de citocinas en cultivos celulares, lo que imita las acciones inmunes e inflamatorias en el cuerpo. El calostro humano posee la mayor concentración, seguido de la leche humana y luego la leche de vaca.
Sin embargo, el remanente menor al 1% del complemento de proteínas en la leche humana comprende una mezcla compleja de proteínas y péptidos bioactivos, la cual está lejos todavía de ser completamente caracterizada y valorada.
La leche humana es el estándar dorado para la nutrición del neonato y el infante. Las inmunoglobulinas secretoras, lisozima, interferón y factores de crecimiento, se conocen como los “beneficios activos” inmunológicos de la leche humana. Este líquido promueve parcialmente la inhibición de patógenos bacterianos y favorece el crecimiento de una microbiota colónica protectora. Además de proporcionar nutrición básica al recién nacido, la leche también protege al neonato y a la glándula mamaria contra infecciones; los recién nacidos alimentados al seno materno experimentan normalmente una menor incidencia de infecciones gastrointestinales así como menos desórdenes inflamatorios, respiratorios y alérgicos. Estos beneficios han sido asociados con diversos factores protectores de la leche materna. Una actividad biológica específica en la leche materna ha sido reportada como la acción del cúmulo de diferenciación CD14 soluble (sCD14, por sus siglas en inglés) –los cúmulos de diferenciación son moléculas marcadoras en la superficie celular, que reconocen ciertos anticuerpos, usadas para la identificación del tipo de célula, estadio de diferenciación celular y actividad de la misma-; el estudio reveló un papel clave para sCD14 durante la colonización bacteriana del intestino, proponiendo que sCD14 está implicado en la modulación de las respuestas inmunes locales tanto innata como adaptativa, controlando la homeostasis en el intestino neonatal. Otro estudio relacionado reveló una interacción entre el receptor tipo Toll soluble 2 (sTLR2, por sus siglas en inglés) y sCD14 en plasma y leche, sugiriendo un nuevo mecanismo de inmunidad innata que puede regular el disparo del receptor tipo Toll regulado microbiológicamente.
Los papeles potenciales de los péptidos derivados de alimentos en la reducción del riesgo de enfermedad cardiovascular han sido ampliamente estudiados, con respecto a sus propiedades benéficas para la presión arterial, el estrés oxidativo, la homeostasis, el apetito y el metabolismo de lípidos. Los efectos benéficos de los lactopéptidos en la hipertensión se ha conocido por largo tiempo; los tripéptidos valil-prolil-prolina (Val-Pro-Pro o VPP) e isoleucil-prolil-prolina (Ile-Pro-Pro o IPP) pueden inhibir la enzima convertidora de angiotensina (ACE, por sus siglas en inglés) in vitro y son producidos por fermentación de la leche por Lactobacillus helveticus y Saccharomyces cerevisiae; esta leche fermentada ha sido usada como alimento para ratas, resultando en una disminución de la presión arterial. Varias pruebas aleatorizadas controladas en humanos han mostrado un efecto hipotensor de los péptidos VPP e IPP derivados de la leche; en sujetos fineses y japoneses con hipertensión leve, se encontró que la presión arterial se redujo en aproximadamente 5 mm Hg durante 4-12 semanas de suplementación de IPP+VPP. El mismo efecto sugerido de estos lactotripéptidos en la presión arterial ha sido rexaminado recientemente en otras 6 pruebas clínicas controladas por placebo y doble ciego, involucrando a 780 sujetos con presión arterial elevada a normal o hipertensión sin tratar en el Reino Unido y en Holanda, en periodos de intervención que duraron de 4 a 8 semanas, con una ingesta de IPP+VPP que iba de los 2 mg/día a los 10 mg/día; en contraste con pruebas anteriores, se encontró poca evidencia de un efecto hipotensor de IPP+VPP y ninguna evidencia de inhibición de ACE en estos últimos estudios. Aun así, aunque los datos más recientes no apoyan un papel de los lactotripéptidos en la regulación de la presión arterial, no se puede excluir un efecto benéfico en sujetos hipertensos de poblaciones específicas, tales como la finesa y la japonesa.
Las bioactividades de los péptidos “escondidos” en las principales proteínas de la leche están latentes hasta que son liberados y activados, ya sea por medio de un tratamiento alimentario-tecnológico o durante la digestión gastrointestinal; los péptidos bioactivos pueden ser producidos in vivo luego de la ingestión de proteínas lácteas y la maquinaria proteolítica de las bacterias utilizadas en la fermentación (yogurt o quesos, por ejemplo) pueden contribuir a la liberación de péptidos bioactivos o a sus precursores. En 2006 apareció el término ‘criptoma’ para aludir al juego “durmiente” de péptidos que residen en el proteoma; se ha promovido el concepto de que estos péptidos crípticos (o “cripteínas”, como también se les conoce), con sus varias bioactividades, pueden ser liberados de la proteína madre vía separación proteolítica. La proteómica es la plataforma obvia para estudiar dichos “criptomas”.
Péptidos bioactivos de la soya
Existe una tendencia actual hacia la búsqueda de fuentes alternativas de proteínas de alta calidad, ya sea por razones de economía (las plantas son más económicas que las carnes), ecología y sustentabilidad (producir proteínas vegetales es menos demandante de recursos que para la producción de proteínas animales) o preferencia del consumidor (veganos o vegetarianos). En consecuencia, los genomas de los substitutos vegetales para las proteínas animales, incluyendo trigo, soya y otras leguminosas, están siendo explorados intensamente en relación a su valor nutritivo y al contenido de bioactivos específicos.
La soya es una fuente geográficamente bien establecida de proteína alimentaria completa, que proporciona cantidades elevadas de todos los aminoácidos esenciales. Sus beneficios reportados a la salud son atribuidos principalmente a sus isoflavonas, saponinas, proteínas y péptidos. Los compuestos bioactivos no son solo típicamente las proteínas de soya como tales sino también los fitoquímicos, sugiriéndose efectos sinérgicos entre ambos. Lunasina, el inhibidor Bowman-Birk, lectina y β-conglicinina son algunos de aquellos péptidos y proteínas biológicamente activos; Lunasina es un nuevo bioactivo de soya que puede detener la división de células cancerosas en un modelo ratón de cáncer de piel, e inhibir la acetilación de histona en células mamíferas. Las respuestas proteómicas y metabolómicas a la soya, incluyendo, entre otros, a isoflavonas, polifenoles y carotenoides, son objeto de estudios continuos, por lo que los hallazgos aparecen continuamente en las publicaciones especializadas.
Adicionalmente, están surgiendo nuevos enfoques para separar y caracterizar más específicamente los péptidos bioactivos en la soya; por ejemplo, se está investigando la capacidad antioxidante de los péptidos proteolíticamente liberados de aislados de proteínas de soya. Estos hallazgos pueden abrir nuevas aplicaciones nutricionales, dado que las moléculas con capacidades para eliminar radicales libres pueden prevenir y tratar las enfermedades asociadas al exceso de estrés oxidativo.
Descubrimiento de péptidos bioactivos, del tamizado clásico a la ingeniería inversa del genoma
Existen métodos in silico e in vitro para descubrir e identificar péptidos bioactivos (nuevos o conocidos) en las fuentes alimentarias. El enfoque clásico in vitro comienza con una fracción o extracto funcional, que contiene potencialmente bioactivos. Estas mezclas de péptidos son típicamente probadas in vitro, por ejemplo, por sus propiedades ligadoras de receptor. Una vez se ha identificado una fracción o extracto interesante, este experimenta un fraccionamiento adicional y subsecuente análisis proteómico y peptidómico a fin de reducir el número y finalmente identificar el(los) principio(s) activo(s). El proceso proteómico y peptidómico típicamente basado en espectrometría de masas debe ser adaptado a la complejidad y heterogeneidad de péptidos bioactivos nativos de longitud completa. Los últimos difieren de los péptidos típicamente trípticos que son más similares en tamaño y en los aminoácidos terminales del extremo C terminal, y son generados para identificación de proteínas en el negocio de los biomarcadores. Existen varias revisiones sobre las herramientas proteómicas y peptidómicas para el descubrimiento y caracterización de bioactivos y sobre cómo estas técnicas difieren del descubrimiento clásico de biomarcadores de proteínas.
Varios grupos de investigadores siguen otra estrategia complementaria, basada en bioinformática, para descubrir y evaluar péptidos bioactivos, en un enfoque denominado “ingeniería inversa del genoma”, que permite el descubrimiento y predicción in silico de péptidos bioactivos. Primero, el dominio científico público puede ser buscado para los péptidos bioactivos conocidos a la fecha y sus funciones sugeridas. Estas secuencias pueden ser mapeadas en genomas alimentarios apropiados en el mundo vegetal o animal a fin de revelar en donde pueden estos péptidos estar residiendo en secuencias de proteínas madre. Tres técnicas de mapeado de secuencia pueden ser desplegadas para este propósito: similitud local, búsqueda de patrón y búsquedas de motivo/perfil, con las dos últimas ofreciendo una mayor sensibilidad y especificidad, a costo de menor velocidad. La similitud local busca peso de aminoácidos de manera equitativa en la secuencia a ser buscada, mientras que la búsqueda de patrón busca los pesos de aminoácidos diferencialmente, de acuerdo a su posición a lo largo de la secuencia. En un análisis adicional in silico, las condiciones digestivas humanas o asociadas al procesamiento alimentario pueden ser imitadas para revelar la liberación proteolítica potencial de péptidos bioactivos a partir de sus secuencias madre. El resultado de este enfoque bioinformático basado en secuencia es un juego de secuencias conocidas de péptido bioactivo, encontrado en y potencialmente liberado de los genomas de los alimentos, a los cuales puede darse seguimiento in vitro e in vivo. Evidentemente, este enfoque de arriba hacia abajo puede reducir significativamente el número de pruebas de bioactividad a realizarse y ayuda a filtrar los candidatos nutricionalmente relevantes y factibles.
Idealmente uno preferiría expandirse a partir de este enfoque dependiente del conocimiento en la literatura (basado en péptidos con beneficios a la salud reportados o sugeridos) hacia secuencias de péptidos en general, pero la predicción de bioactividad basada solamente en la secuencia de aminoácidos no es factible todavía.
Genomas microbianos intestinales
Los humanos y otros mamíferos están colonizados por una comunidad compleja y dinámica de microrganismos. Los adultos humanos son, en términos de número de células, más procarióticos que eucarióticos, con una estimación de que más del 90% de nuestras células son microbianas y solamente el 10% humanas. Se estima que el impacto de este consorcio microbiano en la fisiología humana es sumamente importante en el intestino, dado que este órgano alberga por mucho la mayoría de estas bacterias. Las densidades microbianas en el intestino delgado proximal y medio son relativamente bajas, pero se incrementan marcadamente en el intestino delgado distal (≈108 bacterias/ml de contenido luminal) y el colon (1011-1012 bacterias/gramo.
La microbiota en el cuerpo humano adulto comprende una enorme biomasa superior a los 100 mil millardos de bacterias esparcidas en más de 400 especies, las cuales exhiben intensa actividad metabólica, predominantemente en el colon, y juega un importante papel fisiológico en el anfitrión. En el tracto gastrointestinal (GIT, por sus siglas en inglés), la materia procedente del alimento interactúa y es metabolizada parcialmente por una enorme cantidad y diversidad de bacterias residentes en el estómago y, particularmente, en el intestino.
Los microbios intestinales pueden ser interpretados como un órgano colectivo metabólicamente activo, que afecta el metabolismo energético y la inmunidad del anfitrión. La microbiota puede degradar una variedad de substancias dietarias que de otra forma serían no digeribles y por tanto inaccesibles para el anfitrión; un ejemplo es la obtención de energía a partir de carbohidratos. También se ha demostrado que la colonización del GIT por bacterias comensales influye en la fisiología intestinal del anfitrión mediante la modulación de genes involucrados en la absorción de nutrimentos, la función inmune de la mucosa gastrointestinal y el metabolismo xenobiótico. Una de las funciones centrales de la microbiota colónica es su capacidad para resistir la colonización por alguna cepa nueva de bacterias externas.
Es un enorme reto simular la compleja interacción bacteria-mucosa inmune que se realiza en los modelos in vivo. En uno de dichos intentos, se ha elucidado los eventos metabólicos concomitantes a la aclimatación de ratas libres de gérmenes (GF, por sus siglas en inglés) a condiciones estándar de laboratorio. A fin de revelar los efectos microbianos intestinales bajo condiciones fisiológicamente relevantes, los animales con un GIT estéril a priori y luego monocolonizados con probióticos son ahora utilizados como un modelo apropiado, especialmente los ratones gnotobióticos (en los cuales solamente ciertas cepas conocidas de bacteria y otros microrganismos están presentes), pero también los cerdos GF. El último modelo ha sido reclutado para investigar cómo la colonización bacteriana afecta el proteoma intestinal porcino: los patrones de expresión de proteínas del intestino delgado en cerdos gnotobióticos mantenidos GF o monoasociados con Lactobacillus fermentum o Escherichia coli no patogénica revelaron que la colonización bacteriana afecta diferencialmente la proteólisis, la proliferación epitelial y el metabolismo de lípidos, lo que confirma estudios en otros modelos animales GF.
La metabolómica es apropiada y empleada con mayor frecuencia para capturar las interacciones metabólicas entre el metabolismo del anfitrión y los microrganismos de, por ejemplo, la microbiota colónica. Por ejemplo, el perfilado de metabolitos ha sugerido una contribución de la microbiota intestinal al fenotipo de hígado graso en los ratones resistentes a la insulina: la relación entre la microbiota intestinal y el metabolismo anfitrión con respecto al deterioro inducido por la dieta en la homeostasis de glucosa y la enfermedad del hígado graso no alcohólico (NAFLD, por sus siglas en inglés) en una cepa de ratones susceptible a estos rasgos fue investigada por metabotipado en plasma y orina; la predisposición genética de la cepa de ratones a la homeostasis de glucosa deteriorada y NAFLD ha sido correlacionada con una alteración en el metabolismo de colina, con algunos de los metabolitos de colina siendo coprocesados por la microbiota simbiótica intestinal y los sistemas enzimáticos mamíferos.
La metabolómica también ha facilitado una correlación entre la diversidad del fenotipo metabólico humano y la dieta con la presión arterial, respectivamente. Se ha comparado a ratones GF colonizados por una flora de bebé humano (HBF, por sus siglas en inglés) o una flora normal para ratones convencionales al nivel de microbiología, el perfilado metabólico por resonancia magnética nuclear de protón (1H-NMR, por sus siglas en inglés) de hígado, plasma, orina y lavado del íleon, así como por análisis dirigido de ácidos biliares y ácidos grados de cadena corta en el ciego. Una asociación de metabotipos específicos con el microbioma residente se vuelve aparente, revelando que la HBF tiene una red de correlación microbioma/metaboloma notablemente simple con un impacto directo en la habilidad del anfitrión para metabolizar lípidos. En general, este estudio señala que el microbioma modula globalmente la absorción, el almacenamiento y la obtención de energía a partir de la dieta.
Siguiendo las mismas líneas, grupos de investigación han estudiado la modulación probiótica de las interacciones microbios intestinales-anfitrión en un modelo ratón con un microbioma humanizado: los efectos metabólicos de la exposición a Lactobacillus paracasei o Lactobacillus rhamnosus fueron medidos en ratones HBF y generaron una vista a nivel de sistemas de la respuesta del anfitrión a la intervención probiótica. La exposición a probióticos derivó en la modificación del microbioma y resultó en una alteración en el metabolismo hepático de lípidos, acompañada por menores niveles de lipoproteína en plasma y aparentemente estimularon la glicólisis.
En otro estudio de la microbiota relacionado a desórdenes digestivos, se empleó un modelo inducido por Trichinella spiralis de síndrome de intestino irritable (IBS, por sus siglas en inglés) para investigar los efectos de los probióticos en la disfunción intestinal a nivel de metaboloma. El perfil metabólico en plasma de ratones infectados con T. spiralis mostró una elevación en el metabolismo energético y la movilización de grasa, así como una interrupción del metabolismo de aminoácidos, debido a un incremento en la degradación de proteínas, los cuales estuvieron asociados a la hipercontractilidad intestinal. El incremento en las concentraciones de taurina, creatina y glicerofosforilcolina en los músculos yeyunales estuvo asociado con la hipertrofia muscular y una interrupción de las funciones yeyunales. El tratamiento con L. paracasei normalizó la actividad muscular y el metabolismo energético alterado. Por último, niveles alterados de metabolitos plasmáticos (glutamina, lisina, metionina), posiblemente asociados a respuestas inmunológicas moduladas, fueron también observados con el tratamiento probiótico.
La microbiota intestinal también ha sido investigada en el contexto del metabolismo energético del anfitrión. Sin embargo, todavía debe probarse si las diferentes poblaciones microbianas intestinales son una causa o una consecuencia de, por ejemplo, un desarreglo en el metabolismo energético, como en los sujetos obesos y diabéticos. Estudios recientes han mostrado que los ratones GF son resistentes a la obesidad cuando consumen una dieta alta en grasas (HF, por sus siglas en inglés) y alta en carbohidratos (HC, por sus siglas en inglés), pero los mecanismos involucrados en el fenotipo antiobesidad no han sido identificados, como tampoco ha sido definido si los ratones GF desarrollan resistencia a la insulina y dislipidemia con la dieta HF-HC. Para arrojar más luz a este tema, se ha comparado las consecuencias metabólicas de la alimentación HF en ratones GF y ratones convencionales; los ratones GF consumieron menos calorías, excretaron más lípidos fecales y pesaron significativamente menos que los ratones convencionales: tanto los animales GF/ HF fueron más sensibles a la insulina y tolerantes a la glucosa, mostrando reducción en la insulinemia en ayuno y no ayuno, y teniendo niveles reducidos de TNF-α en plasma y amiloide A sérico total. La hipercolesterolemia reducida, una acreción moderada de colesterol hepático y un incremento en la excreción fecal de colesterol sugieren una alteración del metabolismo de colesterol en los ratones GF/HF. Los resultados muestran que una menor ingesta energética y un incremento en la excreción de lípidos contribuyeron al fenotipo resistente a la obesidad de los ratones GF/HF y revelan que la sensibilidad a la insulina y el metabolismo de colesterol son objetivos (targets) metabólicos influenciados por la microbiota intestinal. Adicionalmente y más importante aún, los datos de la relación entre la microbiota y la obesidad están también disponibles eh humanos; se ha caracterizado un microbioma intestinal asociado a la obesidad, con un incremento en la capacidad para la cosecha de energía: dos grupos de bacterias benéficas son dominantes en el intestino humano, los Bacteroidetes y los Firmicutes. Se ha demostrado una proporción relativamente menor de Bacteroidetes en las personas obesas, comparadas con las personas delgadas, revelando que esta proporción se incrementa con la pérdida de peso en dos tipos de dietas bajas en energía.
Nuestra comprensión molecular sobre cómo los miembros de la microbiota intestinal degradan polisacáridos complejos se deriva de estudios en Bacteroides thetaiotaomicron, un abundante componente del intestino normal en humanos y ratones. La colonización de ratones GF con B. thetaiotaomicron (o Btheta, como se le conoce) ha mostrado cómo este anaerobio modifica la diferenciación celular intestinal y la expresión génica para el beneficio mutuo tanto del anfitrión como del microbio. El proteoma de Btheta comprende funciones específicas para la adquisición e hidrólisis de polisacáridos en un sistema sensible al ambiente. Comparado con el comensal y probiótico Btheta, Bifidobacterium longhum, un miembro menor pero un probiótico comúnmente utilizado, tiene una maquinaria de degradación de glucanos más restringida pero un repertorio mayor de transportadores, sugiriendo que B. longhum se puede beneficiar directamente de la degradación de polisacáridos realizada por Btheta.
El modelo gnotobiótico de ratón sirve como una situación controlada que permite el estudio de cómo una bacteria residente en el intestino y una especie probiótica se adaptan mutuamente a la utilización de sustrato. El modelo también muestra las muchas dimensiones y la especificidad de la relación entre el anfitrión, un componente genérico de su microbiota y los microbios consumidos intencionalmente como los probióticos. Los estudios pioneros demostraron que la ecología intestinal es extremadamente compleja y requiere un enfoque de metagenómica a nivel ecosistema para comprender el impacto en la salud de la microbiota intestinal y los probióticos. Lógicamente, la nutrigenómica puede por lo tanto ser extendida vía metagenómica hacia la metaproteómica, recolectando información de los tres proteomas (anfitrión, alimento y microrganismos). Mientras que técnicas como las micromatrices (microarrays9 y el secuenciado de alto rendimiento han proporcionado datos completos sobre la estructura de la población bacteriana intestinal, más recientemente la pregunta a cambiado de “quién está ahí” a “quién está haciendo qué”, o sea, de un censo de población a un perfil de actividad, siendo esto último facilitado por los análisis metaproteómicos. El último enfoque agrega el desafío adicional, típico de la proteómica, de un (meta)proteoma siendo mucho más complejo que un (meta)genoma.
El campo de la ecología microbiana intestinal ha proporcionado algunos primeros ejemplos de estudios de interacción transgenómica, investigando la comunicación entre la microbiota intestinal y el anfitrión humano vía el metabolismo anfitrión/huésped. Estos estudios no toman necesariamente un enfoque de genoma completo, pero sin embargo se embarcan en el principio de la interacción de los tres “omas”, el metaboloma intestinal, el genoma del anfitrión y el microbioma. Por ejemplo, muy recientemente se ha publicado una perspectiva metagenómica del proceso de envejecimiento en el intestino humano, introduciendo a los seres humanos como “metaorganismos” con una visión más holística del proceso de envejecimiento, tomando en consideración la interacción entre ambiente, microbiota intestinal y anfitrión. Los cambios fisiológicos asociados a la edad en el GIT, el estilo de vida, el comportamiento nutricional y el sistema inmune del anfitrión afectan el ecosistema microbiano intestinal. Luego de revisar el conocimiento actual de los cambios microbianos en las personas al envejecer, se ha propuesto que los desbalances microbianos intestinales asociados a la edad están involucrados en el “inflamaenvejecimiento” y la inmunosenectud. En virtud de la importancia de la homeostasis microbiana intestinal para la salud del anfitrión, se considera intensamente las aplicaciones médicas y nutricionales basadas en preparaciones probióticas y prebióticas específicas para el anciano, con varias pruebas clínicas terminadas y en proceso que reportan el uso de prebióticos/probióticos en el anciano.
Se ha investigado la relación entre las células dendríticas (DC, por sus siglas en inglés) intestinales humanas, la microbiota intestinal y la actividad de la enfermedad de Crohn (CD, por sus siglas en inglés), encontrándose que la producción de interleucina 6 (IL-6) por las DC intestinales es incrementada en los pacientes de CD y se correlaciona con la actividad de la enfermedad y la proteína C-reactiva (CRP, por sus siglas en inglés). En términos de interacción anfitrión-microbio, se ha sugerido que la producción local de IL-6 regida bacterianamente por las DC intestinales del anfitrión puede resultar una función efectora sin oposición y daño tisular. Esto significaría que la función de DC intestinal puede estar influenciada por la composición de la microbiota comensal.
También recientemente se ha estudiado la degradación de los componentes de la matriz extracelular por metaloproteasas derivadas de bacterias así como las posibles implicaciones para la enfermedad inflamatoria del intestino (IBD, por sus siglas en inglés). La degradación proteolítica de la matriz extracelular es una marca distintiva de la homeostasis mucosa y la renovación tisular, pero también contribuye a complicaciones de inflamación intestinal. No se sabe si esto se deriva enteramente del anfitrión, o es parcialmente exhibido por la microbiota intestinal. Por tanto, se tamizaron colonias bacterianas fecales de 20 controles sanos, 23 sujetos con colitis ulcerativa (UC, por sus siglas en inglés) y 18 pacientes de CD para actividad gelatinolítica. Los genes de metaloproteasa fueron detectados por reacción en cadena de polimerasa (PCR, por sus siglas en inglés). El significado fisiológico y las implicaciones potenciales de dicha degradación de matriz regida por microbios fueron confirmadas por una reducción en la resistencia transepitelial (TER, por sus siglas en inglés) luego de la exposición de colon distal de rata a supernadantes de cultivo de Clostridium perfringens. El grupo concluyó que la actividad proteolítica microbiana tiene la capacidad para contribuir a la homeostasis de la mucosa y puede participar en la patogénesis de IBD.
El genoma humano
Los humanos adultos saludables varían considerablemente en su apariencia, desempeño físico y desempeño cognitivo, así como en sus preferencias alimentarias y requerimientos. La nutriología ha reconocido que diferentes situaciones y fases de la vida requieren una ingestión de alimento adaptada adecuadamente, de manera que las mujeres embarazadas, los atletas activos y los ancianos tienen requerimientos dietarios muy distintos y específicos. Las elecciones individuales de alimentos y las soluciones personalizadas tienen una larga historia de ser una consecuencia de preferencia, cultura, etapa vital, y también, como se ha descubierto recientemente, del estilo de vida, la enfermedad y la genética.
La genética clarifica la predisposición a la dieta y la salud
La nutrigenética investiga la predisposición genética de un individuo con respecto a su respuesta a la dieta. Los polimorfismos de un nucleótido (SNP, por sus siglas en inglés) son mutaciones de una sola base en los genes, y son considerados en la actualidad como las diferencias genéticas interindividuales más comunes e importantes a nivel de secuencia génica. Dicho esto, otras modificaciones genéticas, tales como deleciones, inserciones y variantes en el número de copias (CNV, por sus siglas en inglés) son importantes y contribuyen a la variabilidad interindividual en humanos. Los SNPs pueden ocurrir tanto en exones como en intrones (regiones codificadoras y no codificadoras del DNA) y algunos poseen importantes consecuencias funcionales. Se cree que los enfoques regidos por hipótesis para valorar las variantes de genes específicos metabólica relevantes en sujetos inscritos en intervenciones nutricionales, puede mejorar el diseño de estudios y los resultados. Un escenario prometedor está basado en las pruebas de variantes genéticas en las G-proteínas (proteínas heterotriméricas ligadoras de guanina), por varias razones, como se explica a continuación: las G-proteínas son expresadas en todas las células del cuerpo humano. Su función principal es traducir señales de la superficie celular hacia una respuesta celular. Representan un embudo de señalización de unas 30 proteínas, posicionadas entre miles de señales extracelulares, cientos de receptores de membrana y otra vez miles de moléculas efectoras intracelulares. Las G-proteínas son heterodímeros y consisten de subunidades alfa, beta y gamma codificadas por genes diferentes. Esta composición de subunidades alfa, beta y gamma determina su especificidad de receptor y efector. Dado el papel crucial de las G-proteínas en virtualmente todos los procesos de transducción de señal intracelular, se ha demostrado que las mutaciones que alteran las expresiones o estructura de estas proteínas pueden contribuir y aún causar desórdenes a la salud.
Los SNPs metabólicamente relevantes en G-proteínas han sido caracterizados extensamente. Se ha demostrado que las variantes en los genes asociados a G-proteínas impactan directamente la regulación del peso corporal; se realizó el genotipado de 111 participantes de una prueba clínica aleatorizada controlada por placebo para el polimorfismo GNB3 C825T (el gen GNB3 corresponde al polipéptido beta 3 de la G-proteína) y el análisis de las asociaciones de genotipos con el resultado de un programa estructurado de disminución de peso con la administración de un placebo o 15 mg de sibutramina diariamente por 54 semanas. El polimorfismo C825T en la subunidad β3 codificada por el gen GNB3 podría predecir si una reducción de peso bajo terapia con sibutramina sería exitosa o no. Una observación similar ha sido realizada para el gen GNAS que media el incremento en cAMP en varios tipos celulares luego de la estimulación hormonal (este locus tiene un patrón de expresión de impronta altamente complejo que da origen a transcriptos expresados maternalmente, paternalmente y bialélicamente, que son derivados de 4 promotores alternativos y exones en el extremo 5’); el genotipo GNAS G(-1211)A, también influencia la respuesta individual a la intervención de pérdida de peso inducida por sibutramina. Por último, el genotipo GNA11 G(-659)C en la G-proteína Ga11 también tiene una fuerte influencia en la intervención con sibutramina. En conjunto, estos resultados sugieren que el genotipado dirigido a las G-proteínas puede rendir intervenciones nutricionales más específicas y poderosas.
La mayoría de los estudios de G-proteína en poblaciones caucásicas revela una asociación positiva entre el estatus del portador del alelo 825T en la subunidad GNB3 por un lado y un incremento en el riesgo de hipertensión por otro lado. Esto ha sido mostrado en particular para grandes poblaciones genotipadas dentro de un estudio germano-belga. Adicionalmente, surge evidencia de que la frecuencia del alelo 825T está incrementada en los pacientes hipertensos con características típicas de síndrome metabólico; los portadores del alelo 825T que son normotensos, jóvenes y delgados, revelan los primeros signos del síndrome metabólico, tales como un incremento en la concentración de colesterol total y de ácido úrico, pero no resistencia a la insulina (desarreglos metabólicos similares fueron encontrados en adultos maduros europeos y japoneses). En sujetos hipertensos de mayor edad que poseen el genotipo TT o TC de GNB3, la resistencia a la insulina parece ser más frecuente que en los individuos con el genotipo CC. En conjunto, los estudios discutidos aquí resaltan la cuestión de si la hipertensión asociada con el polimorfismo C825T puede ser solo una faceta del síndrome metabólico. La asociación de 825T con el riesgo incrementado de diabetes mellitus tipo 2 (T2DM, por sus siglas en inglés) todavía debe ser confirmada.
En virtud de la evidencia mostrada arriba, el genotipado de voluntarios adultos saludables, inscritos en pruebas de manejo de peso corporal a nivel de G-proteína parece prometedor y complementario para probar otros genes metabólicamente relevantes para la caracterización del sujeto u la estratificación de la cohorte.
Un contexto nutrigenético más médico y dirigido a prevenir enfermedades está dado por una base genética de los defectos en tubo neural (NTD, por sus siglas en inglés), cáncer y su correlación con folato y metabolismo de metionina. Una substitución C→T en el gen que codifica la metilentetrahidrofolatorreductasa (MTHFR, por sus siglas en inglés), la enzima que produce 5-metiltetrahidrofolato (o 5 metil-THF), requerido para la conversión de homocisteína a metionina, es bastante común. Los individuos con el genotipo T/T exhiben efectos metabólicos funcionales, como cambios en los derivados de folato de un carbono, elevación de homocisteína en plasma y diferente respuesta a la suplementación con ácido fólico, comparados con los genotipos normal (C/C) y heterocigoto (C/T). Estos cambios metabólicos asociados con el genotipo T/T pueden modificar el riesgo para enfermedad crónica (enfermedad vascular y cáncer) y NTD si coinciden con deficiencia de folato. Luego de estudiar la modulación de estas desviaciones metabólicas mediante el incremento en la ingestión de folato, los investigadores han concluido que los requerimientos de folato pueden ser diferentes en los individuos afectados (T/T), relativos a los individuos normales (C/C) o heterocigotos (C/T).
La suplementación efectiva con folato previene la ocurrencia de NTD. Junto con los niveles elevados de homocisteína en sangre en las madres con niños NTD, esto sugiere que los genes de folato -metilentetrahidrofolatorreductasa (MTHFR) y metilentetrahidrofolatodeshidrogenasa (MTHFD)-, así como los genes del metabolismo de cisteína –metionina sintetasa, metionina sintetasa reductasa y cistationina sintetasa- pueden estar involucrados en la etiología de NTD.
La epigenética para comprender la programación metabólica
Epigenética significa “sobre la genética” y alude a mecanismos que controlan la expresión sin cambiar la secuencia del DNA. Los cambios epigenéticos comprenden modificaciones moleculares tanto en el DNA como en la cromatina. La metilación del DNA y cambios en el empaque de cromatina por modificaciones postraduccionales de las proteínas de histona son los mecanismos más extensamente investigados. Otros eventos epigenéticos incluyen la regulación de los RNAs no codificadores, tales como los microRNAs, y mecanismos que controlan la organización de alto nivel de la cromatina dentro del núcleo. Además de la relevancia para la programación ambiental, los mecanismos epigenéticos son elementos centrales del desarrollo y la diferenciación, pues la regulación epigenética está involucrada en la expresión y silenciado génicos específicos para cada tejido.
La epigenética proporciona un marco bioquímico para los efectos a largo plazo de las experiencias ambientales, la programación metabólica y el desarrollo adaptativo. Los cambios epigenéticos suceden más comúnmente durante la gestación, el desarrollo neonatal, la pubertad y la edad avanzada. Durante la embriogénesis temprana, el genoma mamífero es “limpiado” de la mayoría de las marcas epigenéticas, siendo éstas luego restablecidas progresivamente durante el desarrollo embrionario. El epigenoma es por tanto más vulnerable ambientalmente durante la embriogénesis. Las marcas epigenéticas pueden ser heredadas de una generación a la siguiente, ya sea directamente por conservación a través de la meiosis, o indirectamente en la siguiente generación a través de replicación de las condiciones en las cuales el cambio epigenético sucedió en primer lugar. Estas observaciones acumulan evidencia substancial para los orígenes evolutivos (durante el desarrollo) de la salud y la enfermedad, con mecanismos epigenético subyacentes.
Caracterizar los perfiles de expresión de genes controlados epigenéticamente debería revelar biomarcadores tempranos para enfermedad, exposición, intervención y eficacia. En segundo lugar, estos marcadores deberían traducirse en diagnóstico temprano de individuos con propensión para la enfermedad de aparición en la vida adulta y pueden finalmente proporcionar enfoques terapéuticos novedosos que prevenga y traten las enfermedades antes de que los síntomas clásicos se hagan visibles. Esto contrasta con el manejo actual de la enfermedad en humanos, el cual típicamente está dirigido a tratar y curar las enfermedades luego de su aparición. A este respecto, puede esperarse que la epigenética juegue un papel clave en la nutrición; la investigación moderna en nutrición se enfoca en la prevención de enfermedad y la conservación de la salud. Ultimadamente, el conocimiento completo del epigenoma humano será requerido, pues el epigenoma no es solamente dependiente del tejido y de la etapa de vida, sino que también varía marcadamente entre individuos y entre especies.
La evidencia mecanística actual de la programación epigenética ambiental, por rutas nutricionales u otras, ha sido generada principalmente en estudios animales. La epidemiología humana también ha destacado las asociaciones entre el impacto ambiental –especialmente prenatal y postnatal temprano- y las modificaciones epigenéticas a largo plazo, manifestándose en los fenotipos de salud y enfermedad. La plasticidad del desarrollo de manifiesta generalmente cuando la exposición ambiental produce un amplio rango de fenotipos adultos a partir de un solo genotipo, por alteración epigenética de la expresión génica, pero la plasticidad del desarrollo permite no solamente a un organismo adaptarse a señales ambientales durante la vida temprana, sino que puede también incrementar el riesgo de enfermedades crónicas, especialmente en el caso de un desajuste entre el ambiente percibido en la vida temprana y el encontrado después, durante la vida adulta.
Los organismos en desarrollo parecen ser particularmente susceptibles a los cambios epigenéticos. Los efectos de la nutrición subóptima durante el periodo periconcepcional muestra la ‘sensibilidad epigenética’ de esta fase de desarrollo, en la cual ocurre la reprogramación amplia del epigenoma. También las alteraciones nutricionales posteriores en el embarazo, la sobrenutrición postnatal que lleva a un rápido crecimiento y la sobrenutrición materno-fetal pueden causar la desregulación metabólica en la vida posterior. Para cada una de estas situaciones, se han reportado cambios epigenéticos. La importancia del periodo periconcepcional, cuando la nutrición subóptima puede tener efectos duraderos sin afectar el peso al nacer, subraya la necesidad de una nutrición saludable durante el periodo pre-embarazo, cuando la nutrición puede con frecuencia ser desbalanceada, aun en mujeres de países ricos. De igual forma lo es el hallazgo relacionado de la ingestión (des)balanceada de micronutrimentos involucrados en el metabolismo de un carbono durante el embarazo, afectando la salud metabólica subsecuente de la progenie, lo que tiene implicaciones para la suplementación nutrimental. La investigación en modelos animales fue más allá del análisis y ha demostrad que dichos efectos adversos de la nutrición deteriorada en la vida temprana y los cambios epigenéticos asociados pueden ser prevenidos o revertidos por intervenciones nutricionales (tales como la suplementación con folato) o intervenciones endocrinológicas (tales como la administración neonatal de leptina).
La epigenética en la nutrición debe jugar un importante papel en la investigación mecanística de los efectos a la salud humana a largo plazo de nutrimentos, ingredientes, y posiblemente, dietas completas. En estudios más fundamentales que dependen de modelos animales, la dimensión epigenética de, por ejemplo, promover nutricionalmente la masa corporal magra y la imitación dietaria de efectos de la restricción calórica en la duración de la vida, deben ser explorados.
Los genomas de los alimentos interactúa con el genoma humano, ya sea directamente o mediado por la interfase con el metagenoma microbiano intestinal. Los ácidos grasos polinsaturados, por ejemplo, se unen directamente a factores de transcripción particulares (tales como los PPARs) que a su vez encienden la maquinaria de expresión génica, una interacción particularmente directa entre un componente alimentario y el genoma del anfitrión. Por otro lado, los oligosacáridos derivados de la leche humana favorecen la colonización del intestino infantil con bacterias benéficas para la salud, que a su vez impactan el metabolismo del anfitrión, una interacción indirecta pero poderosa, mediada por la microbiota intestinal entre una clase de compuesto alimentario y el genoma del anfitrión, resultando en una relación simbiótica entre el alimento y la bacteria intestinal.
Esta perspectiva y ejemplos ilustran que necesitamos comprender la regulación y variabilidad del genoma humano como una respuesta a su exposición a los genomas de los alimentos (como los péptidos bioactivos en los lácteos) en conjunto con el microbioma intestinal del anfitrión.
Los alimentos funcionales con valor agregado a la salud comienzan con una perspectiva holística y genómica de cómo podemos nivelar la riqueza de los bioactivos derivados de las fuentes alimentarias, con los péptidos bioactivos derivados de a leche siendo un ejemplo prominente, lo que se refiere a la explotación bioinformática y proteómica de los genomas alimentarios. Luego necesitamos ver en donde, cuando y cómo estos bioactivos interactúan con el cuerpo humano, ya sea de manera directa o metabolizada por el anfitrión o el microbioma intestinal, y cómo estas interacciones se traducen en consecuencias fisiológicas, lo que se refiere a la elucidación a nivel de las ciencias ómicas de los efectos nutricionales a la salud.
Como una importante dimensión de esta interacción alimento-anfitrión, necesitamos tomar en consideración el microbioma intestinal humano como un órgano metabólico, una perspectiva que finalmente requiere un enfoque metagenómico.
En una etapa adicional, las diferencias interindividuales en las respuestas humanas a la dieta deben ser comprendidas, lo que puede ser parcialmente estudiado a través del genotipado de genes metabólicamente relevantes. Debemos monitorear las consecuencias en la salud a largo plazo de la nutrición temprana y en las demás etapas del ciclo vital, y tratar de comprender en cuales tejidos y a qué nivel molecular estos efectos pueden estar mediados por mecanismos epigenéticos.
Aunque los estudios de expresión génica y proteica, así como el perfilado de metabolitos en humanos para investigar respuestas (algo agudas) a las intervenciones nutricionales se han convertido en un estándar para la investigación nutriológica mecanística, tanto la validación como la traducción de los resultados son un desafío. Existen ejemplos emergentes de polimorfismos funcionalmente impactantes en genes metabólicamente relevantes que determinan si un individuo se beneficia o no, y en qué grado, de una dieta o ingrediente específico. No obstante, los alimentos basados en la nutrigenética todavía deben ser desarrollados. Finalmente, estamos solamente comenzando a apreciar cómo la programación epigenética es no solamente una parte natural del desarrollo y la diferenciación, sino también un mecanismo de cambios de expresión génica a largo plazo que resulta en la denominada ‘memoria metabólica’.
La investigación actual y futura de alimentos a nivel molecular deberá hacer preguntas nutricionales precisas, contestarlas en estudios altamente definidos y controlados, desde dietas e ingredientes bien definidos hasta lecturas genómicas estandarizadas, y, más importante aún, valorar los resultados con una multitud de herramientas genómicas y genéticas holísticas, combinadas con un fenotipado extenso.